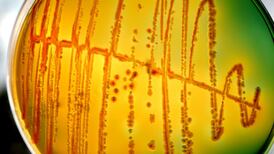
Superbugs poised to become humanity’s greatest killer

Science
Crosswords & Puzzles
Crosswords & puzzles to keep you challenged and entertained
Common Ground
How does a post-Brexit world shape the identity and relationship of these islands
The GlossOpens in new window
Read the digital edition of The Gloss magazine now
Family NoticesOpens in new window
Weddings, Births, Deaths and other family notices